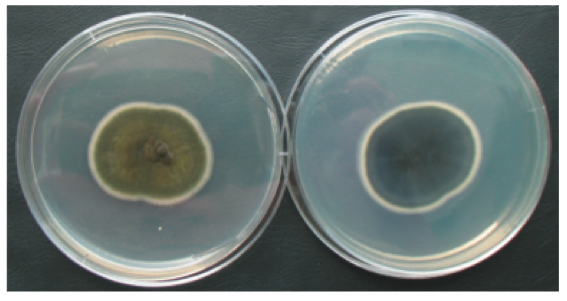

A Rare Human Pathogenic Fungi: Cladosporium
Cedric
NDINGA MUNIANIA
Western
Illinois University
My name is
Cedric NDINGA MUNIANIA a graduate student in the Biological Science Department
at Western Illinois. This is focus
on in fungal infections in general and in particular infections caused by Cladosporium sp. I hope this would raise awareness about
fungal diseases and will increase your interest in the subject.
Cladosporium spp.
![]() |
| Figure 1: Cladosporium conidiophores with chain of blastoconidiahttp://www.microbiologybook.org/mycology/mycology-5.htm |
Taxonomy
Domain: Eukarya
Kingdom: Fungi
Phylum: Ascomycota
Class: Dothideomycetes
Order: Capnodiales
Family: Cladosporiaceae
Genus: Cladosporium
Species: ~60
General
Description
Cladosporium is a genus that belongs to the phylum Ascomycota and includes about 60
species (12). Generally found in the environment as a saprobe (4), this genus is considered as common mold and an airborne fungus along
with Alternaria and Aspergilus (11). Cladosporium is
usually isolated as an environmental contaminant in the laboratory and food
industry (11) and rigorous testing are required before it can be determined as a
causative agent of fungal infections. The Cladosporium genus is a very
diverse group that include species specific to certain geographic areas (12)
and can be isolated as plants pathogen or causing opportunistic human infections
(14). Despite the fact that incidence of fungal infections are low, some
species have been associtated with asthma, rhinitis, chromablastomycosis,
phaehyphomycosis, intrabronchial lesions and cladosporiosis (6,12,14).
The most
common species of Cladosporium are:
_Cladosporium bantiana
associated with central nervous system cladosporiosis (6)
_ Cladosporium cladosporioides : can cause pulmonary and
cutaneous opportunistic infections in
human and animals (13).
_Cladosporium herbarum causes mold allergies and can also cause
skin infection in human and animals (1, 13).
_Cladosporium oxysporum is associated with keratitis and other
skin infection in human (13)
_ Cladosporium sphaerospermum is associated with cases of
corneal ulcer, bronchial infections and onychomycosis (13)
_Cladosporium trichoid
both are associated with case of CNS phaehyphomycosis (4).
Macroscopic
features
Several species of this genus are moderate fast
growers, 4-6 days (10) and growth better at 25°C with a preference for SDA and
PDA (11, 14). However some species are thermotolerant with an optimum
temperature at 42°C (9). Most Cladosporium spp. are usually classified
within the group dematicae due to the melanization of their cell wall (11). Many
species of this genus form pigmented molds ranging from dull olive green to
black in coloration (1) (Figure 2).
![]() |
| Figure 2: Culture of Cladosporium herbarum in Petri dish on PDA medium http://www.livne.co.il/thesis/fungi_pictures/misc/index.html |
Microscopic
features
Cladosporium spp. are characterized by having branched pigmented hyphae from which chains
of blastococonidia will rise (11). Most conidia in the chains measuring 3µm X
6.4 µm (4) will have scars and the tips of the terminal conidiophore usually
has ramoconidia or branched conidia
(12). Figure 3 denote the bud-like chain of blastoconidia formed by Cladosporium.
![]() |
| Figure 3: Holoblastic conidiogenesis associated with Cladosporium http://www.environix.com/mold-iaq-library/mold/cladosporium/. |
Seasonal
variability
Though Cladosporium spp. release spores throughout the entire
year, the amount of spores released follow a seasonal pattern with the peak
being during the summer months (5). Furthermore Cladosporium releases spores
during both wet and dry conditions, but a higher number of spores is released
during the wet and rainy season because spores are easily dispersed by rain
splash (7).
Geographic Distribution:
This fungus is ubiquitous in the environment
and distributed worldwide (11). However some species are limited or dominant to
specific environments. That is the case for C. herbarum that is mainly
found in temperate regions (12) and C. carrionii mainly found in East
Asia (15).
Habitat
Being a saprobes in nature, Cladosporium spp are usually isolated from soil, decaying
organic matter and dead plants
(11). In addition to soil, these massive producers of spore can be isolated from
air and water sample (12). Some species have been isolated from water pipe
line, glass fiber and as a food and textile contaminant (11).
Main
infections and related fungi:
Lower respiratory tract diseases:
Indeed
most Cladosporium spp. produce a lot of spores as well as allergens (12)
leading to allergic reactions with extended exposure. For some people inhaling
the allergens will lead to more complicated conditions such as asthma and
rhinitis (3). C. cladosporioides has been reported as one of the main
cause of air-borne allergies due to fungus (3). However allergens are
effectively produced as the spore are being produced are but they are very low
when the fungi is in the to form (3).
Mycotoxins poisoning
Along with Aspergillus, Cladosporium is
one of the most carcinogenic fungi (11), thus producing high amounts of toxins.
C. cladosporioides produces two strong mycotoxins cladosporin and emodin
as well as some other less toxic compounds (11). Because Cladosporium can
coexist with plants as endophytes (12), it is more likely that consumption of
fruits or leaves of an infected plant will result in mycotoxin poisoning.
Furthermore mycotoxin are resistant to heat which means that consumption of
thoroughly cooked infected food product could still cause health issue in human
(14)
Phaehyphomycosis:
It is a general fungal infection caused by
pigmented mold also called dematiaceous fungi, which includes Cladosporium
spp, Cladophora spp, Exophiala spp, Alternaria spp and Ramichloridium spp (9). This disease starts as a pulmonary infection and can become
disseminated and infect the skin, and could extend to the central nervous
system (9). This particular infection is characterized by the growth of
pigmented hyphae on the infected tissues (6). The Cladosporium spp associated
with this disease includes C. cladosporioides, Cladosporium oxysporum
and Cladosporium sphaerospermum. (8,10,11,13) (Figure 4).
![]() |
Figure 4: Cutaneous Phaehyphomycosis. http://www.hindawi.com/journals/cridm/2011/385803/fig3/
|
Chromoblastomycosis
This is a fungal
infection that mainly infects the skin and subcutaneous tissues and is characterized
by chronic ulcerative granuloma especially on the feet and the legs (9). It is
mainly caused by Cladophora spp, and Exophiala spp, (9) but recent cases
have reported Cladosporium as the causative agent of this disease
including species such as C. cladosporioides , Cladosporium bantiana and Cladosporium trichoides (6) (Figure 5).
![]() |
| Figure 5: chromoblastomycosis caused by cladosporium spp http://www.biomedsearch.com/nih/Chromoblastomycosis-due-to-Cladosporium-carrionii/21814409.html |
Central nervous system cladosporiosis
This
is a rare fungal infection that mainly infects the central nervous system (CNS)
and is caused by Cladosporium, but more precisely Cladosporium
bantiana (6). The defining symptoms for this infection includes fever and intracranial
abscesses, and if not treated , it can lead to diffuse meningoencephalitis with
extensive necrosis (6).
Site of entry
and Population at risk
Cladosporium
is an important air-borne fungus producing a lot of spores (11).
Therefore depending of the type of infection, the fungus enters the body mainly
due to inhalation of spores or allergens (14)
Just
like for other fungal infection, the population at risk for Cladosporium
infections includes immuno-compromised patients and steroid users (6), patients in intensive care unit such
as patients on peritoneal dialysis (11) and on immuno-deficient patients (2).
For many reported cases, the infected patient were farmers or were involves
in a lot of outdoors activities (6). However Cladosporium is not always
pathogenic and can infect healthy patient with no history of previous
fungal infection (8).
Diagnosis and
identification
Diagnosis
of Cladosporium infection can require a combination of technique and
collection of information about patient recent activities and occupations. In
most cases doctor use a combination of direct microscopy and growth of the
fungi on a plate (6). To
begin, tissues from the lesions are harvested and stained using periodic
acid-Schiff (10). Observation of the specimen under the microscope will reveal branched
hyphae darkly pigmented with chains of blastococonidia that are clustered (10)
(Figure 3). Also, samples from the lesion site are plated on SDA or PDA at both
25°C and 37°C for at least two weeks (8). Positive identification Cladosporium
should result in a formation of dark gray to black mold on the plate (8). In
some extreme cases DNA from the sample could be isolated and PCR and sent out
for sequencing of the ITS region for exact identification (10)
Treatment
The treatment for Cladosporium infection
is very hard and depends on the severity of the infections. Most antifungal
drugs available on the market have limited effect against many species of Cladosporium
(6). This resistance of the fungus though unclear, seems to be related to
the presence of melanin in their cell wall (11). Indeed melanin has been
considered to increase the virulence of pathogens by reducing their
susceptibility to host immune system, inhibiting some of the host response
mechanisms as well as the action of some antifungal drugs (16). Furthermore,
some Cladosporium species can have innate resistance to Amphotericin B
(Amp B) (6) and thus requires combination of different drugs to heal the
patient.
Nevertheless
less severe respiratory infection or allergies would just light symptoms or flu
like symptoms and will disappear (11). Mild infections can be treated with
azoles which sometimes need to be combined with flucytosine (4). For example
cutaneous infection due to C.
cladosporioides can be treated with itraconazole and ketoconazole
(10). However the best approach
for systemic infections or deeper organ infections is surgical removal of
infected tissue combined with cure of Amp B associated with azoles (13).
Clinical
cases
Case study I: Intrabronchial lesions
A
healthy 58-year-old woman with no previous record of asthma or respiratory
issues arrived at the hospital complaining about persistent dry cough that had lasted for a month prior coming
to the hospital. Blood tests were performed and came back normal. Serum IgE and
the multiple antigen simultaneous test (MAST) for Aspergillus were also
performed and they all came back negative. In addition to these tests, routine bacteriological, fungal, and
mycobacterial cultures of sputum were performed and the results were negative.
That led the doctors to do chest X-ray (Figure 6a) and CT scanning that revealed a nodular opacity
in the right right basal bronchus (Figure 6b). Based on this results doctor
decided to perform a transbronchial biopsy that revealed presence of
hyphae-like structure on the necrotic tissues. Samples from the lesion were
then collected and cultured on Sabouraud glucose agar for seven day. After
incubation, three grayish green cotton-like colonies were growing on the plates.
Examination of these colonies under the microscope using lactophenol cotton
blue stain revealed brown budding conidia and globular conidiophores, the
defining characteristics of C. sphaerosporum. Thus the patient was diafnosed with Intrabronchial lesion due
to Cladosporium sphaerospermum and was treated with intrabronchial
infusion of amphotericin B (60 mg)
followed by oral administration of prednisolone (10 mg/day) for two
weeks before being switched to oral itraconazole (100 mg/day). The patient
condition really improved after the treatment.
Case study II
A
66-year-old woman that was a gardener and had history of trauma was admitted to
the hospital due to multiple nodular erythematous lesions on her right leg
(Figure 7a). These lesions had a reddish brown coloration and were soft and
elastic. The patient reported that the lesions started as papules a year ago
and had joined forming nodules. Her medical record revealed history of high
blood pressure, hyperthyroidism and sensory motor polyneuropathy. She also
showed symptoms of Cushing syndrome but previous tested came back negative.
Biopsy of the lesions along with histopathological examinations were realized
and revealed normal skin morphology but staining with periodic acid-Schiff
showed septate hyphae and yeast like vesicles. At the same time, sample from
the lesions were inoculated on Sabouraud glucose agar with cycloheximide (an
antibiotic) and incubated at 28 °C. After 6 days of incubation, colonies that velvet olive green on top
and greenish black at the bottom were obersved. Observation of these colonies
under the microscope revealed clustered of blastoconidia attached to a central
branched hyphae (Figure 7b), defining characteristic of Cladosporium
oxysporum. The patient was thus diagnosed with cutaneous phaeohyphomycosis caused by Cladosporium oxysporum. The doctors proposed surgical lesion of the
excision but the patient did not agree. Consequently, she was treated with
itraconazole (200mg/day) for 3 months. After the treatment the nodular lesions
highly leaving some minor scars. However examination fibrotic tissue as
check-up test revealed presence of spetate hyphae similar to the one seen
before. Immunohistochemicals examination showed increased in level of CD8 and CD1a and HLA-Dr, which means
that inflammatory cells were activated. While the hormone profile indicated
increase in urine free cortisol and ACTH level. Based on the first diagnosis
and he latest results, the second diagnosis was pituitary adenoma. This time a
surgical removal of the adenoma had to be performed and itraconazole was
replaced with ketoconazole (3dose/day of 100mg each) for three month. The
patient recover after the treatment, and no recurrence of the infection was
seen after 6 months follow-up.
![]() |
| Figure 7: (a) Nodular lesions on the right leg of the patient. (b) Clusters of conidia typical of Cladosporium oxysporum. |
Taxonomy
challenges
This anarmorphic genus present some challenge
for taxonomy due to the fact that most species have no known teleomorphs (12) and are suspected to have lost the
ability to reproduce sexually (1), while other species are associated with
teleomorphic species, Mycosphaerella (11). Also some of the species previously known as Cladosporium
have been moved to the genera Cladophora and Exophiala (12). That
is the case for Cladosporium devriesii, Cladosporium carrionii
and Cladosporium mansonii which have been renamed respectively to Cladophialophora
devriesii, Cladophialophora carrionii and Exophiala castellanii (12).
Reference
1. De
Hoog GS, Gueho E, Masclaux F, Gerrits van den Ende AH, Kwon-Chung KJ, McGinnis
MR. 1995. Nutritional physiology and taxonomy of human- pathogenic
Cladosporum-Xylohyphy species. J Med Vet Mycol. 33: 339-47.
2. Aglawe V., Tamrakar M., Singh S.M. and
Sontakke H. 2013. Systemic phaeohyphomycosis caused by Cladosporium cladosporioides: in vitro sensitivity and its
serological diagnosis. Advances in Life Science and Technology. 8: 16-20.
3. Bouziane H, Latge JP, Fitting C, Mecheri S, Lelong M, David B.
2005. Comparison of the allergenic potency of spores and mycelium of Cladosporium. Allergol Immunopathol
(Madr) .33: 125-30.
4. Dixon DM, Walsh TJ, Merz WG, McGinnis MR. 1989. Infections due
to Xylohypha bantiana (Cladosporium trichoides). Rev Infect
Dis. 11: 515-25.
5. Fairs A, Wardlaw AJ, Thompson J, Pashley CH. 2010. Guidelines on
ambient intramural airborne fungal spores. J Investig Allergol Clin Immunol.
20: 490-8.
6. Garg N, Devi IB, Vajramani GV, Nagarathna S, Sampath S,
Chandramouli B A, Chandramuki A, Shankar S K. 2007. Central nervous system
cladosporiosis: An account of ten culture-proven cases. Neurol India. 55:282-8
7. Knutsen AP, Bush RK, & Demain JG . 2012. Fungi and allergic
lower respiratory tract diseases. J Allergy Clin Immunol. 129: 280-91.
8. Patterson JW Warren NG, Kelly LW. 1999. Cutaneous phaeohyphomycosis
due to Cladophialophora bantiana. J Am Acad Dermatol. 40: 364-6.
9. Reiss E., Shadomy H. J. & Lyon M G. 2012. Fundamental of Medical Mycology. Hoboken, NJ: Wiley-Blackwell.
10. Romano C, Bilenchi R, Alessandrini C, Miracco C. 1999. Cutaneous
phaeohyphomycosis caused by Cladosporium oxysporum. Mycoses..42(1-2):111-5.
11. Tasic S & Miladinovic N. 2007. Cladosporium spp. – Cause of
opportunistic mycoses. Institute of Microbiology Faculty of Medecin. 24 : 15-19
12. Webster J. & Weber R. W. S. 2007. Introduction to
fungi 3rdedition. New York, NY: Cambridge University press.
13. Yano S, Koyabashi K, Kato K. 2003. Intrabronchial lesion due to
Cladosporium sphaerospermum in a healthy, non-asthmatic woman. Mycoses. 46:
348-50.
14. Ogórek R, Lejman A, Pusz W, Miłuch A, & Miodyńska P. 2012. Characteristics
and taxonomy of Cladosporium fungi. Mikologia Lekarska. 19: 80-85.
15. De Hoog GS, Queiroz-Telles F, Haase G,
Fernandez-Zeppenfeldt G, Angelis DA, van den Ende A, Matos T, Peltrohe-Llacsahuanga
H, Pizzirani-Kleiner AA rainer J, Richard-Yegres N, Vicente V, Yerges F. 2000. Black
fungi: clinical and pathogenic approaches. Med Mycol. 38: 243-50.

I'm 15 years old. I was born with HIV my mother passed away because of the HIV infection And I regret why i never met Dr Itua he could have cured my mum for me because as a single mother it was very hard for my mother I came across Dr itua healing words online about how he cure different disease in different races diseases like HIV/Aids Herpes,Parkison,Asthma,Autism,Copd,Epilepsy,Shingles,Cold Sore,Infertility, Chronic Fatigues Syndrome, Lupus Cure,Fibromyalgia,Love Spell,Prostate Cancer,Lung Cancer,Glaucoma.,psoriasis,Cirrhosis of Liver, Cataracts,Macular degeneration, Chrons disease,Infectious mononucleosis.,Cardiovascular disease,Lung disease.Enlarged prostate,Osteoporosis.Alzheimer's disease,psoriasis,Bipolar Disorder,Dementia.,Tach Disease,Breast Cancer,Blood Cancer,Colo-Rectal Cancer,Love Spell,Chronic Diarrhea,Ataxia,Arthritis,Amyotrophic Lateral Scoliosis,Stroke,Fibromyalgia,Fluoroquinolone ToxicitySyndrome Fibrodysplasia Ossificans ProgresSclerosis,Weak Erection,Breast Enlargment,Penis Enlargment,Hpv,measles, tetanus, whooping cough, tuberculosis, polio and diphtheria)Diabetes Hepatitis even Cancer I was so excited but frighten at same time because I haven't come across such thing article online then I contacted Dr Itua on Mail drituaherbalcenter@gmail.com/ . I also chat with him on what's app +2348149277967 he tells me how it works then I tell him I want to proceed I paid him so swiftly Colorado post office I receive my herbal medicine within 4/5 working days he gave me guild lines to follow and here am I living healthy again can imagine how god use men to manifest his works am I writing in all articles online to spread the god work of Dr Itua Herbal Medicine,He's a Great Man.
ReplyDelete